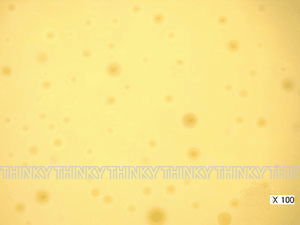

乳胶的搅拌混合-THINKY搅拌机应用
发布时间:2021-01-16 19:19
넶浏览量:0
乳胶
![]() |
![]() |
| 液体石蜡+水(W/O型) | 蛋黄酱(O/W)型 |
乳化是指互不相溶的液体(水和油),通过将其中一种液体微粒子化,使它分散到另一液体中的操作。乳化分为将油粒子分散到水中的O/W型乳液和水粒子分散到油中的W/O型乳液两种类型。照片为使用THINKY的自转公转搅拌机的乳化一例。
上海备得数码科技有限公司作为THINKY的专业销售与服务商,可提供THINKY搅拌机及相关容器配件,以及使用培训和维修售后等,如有相关需求欢迎来电咨询!
如需了解更多THINKY产品,欢迎访问https://ibetter.com/thinky
- 2019-01-01
- 2020-05-20
- 2015-11-05
- 2020-05-13
- 2019-12-03
- 2019-11-13
- 2022-04-12
- 2019-08-01
- 2019-08-01
- 2019-12-06
- 2021-11-06
- 2020-02-26